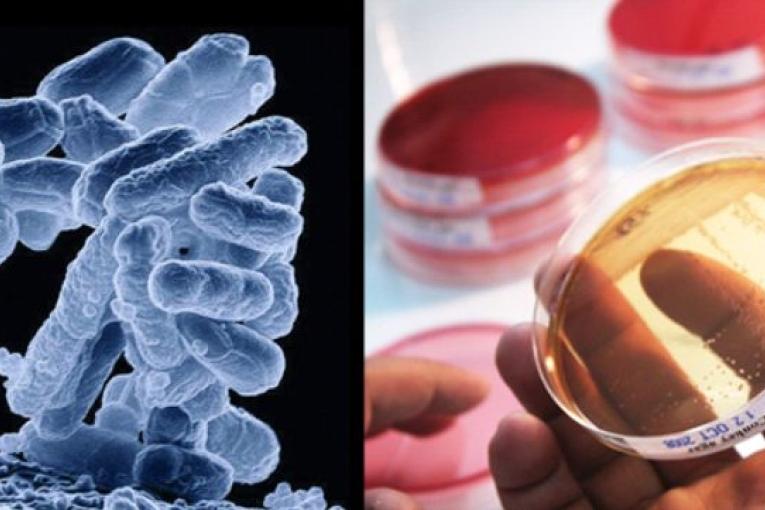

Rapport de l’OMS sur la résistance aux antibiotiques : MSF confirme l’état d’urgence
Communiqué de presse
Pour MSF, il est urgent de mieux documenter les antibiorésistances et d'agir pour en limiter la propagation.
L'Organisation mondiale de la santé (OMS) a présenté mercredi 30 avril son premier rapport sur la résistance aux antibiotiques. Ce travail inédit met pour la première fois en avant une inquiétante diffusion des bactéries résistantes aux antibiotiques à l'échelle mondiale. Pour Médecins Sans Frontières (MSF) ce document doit constituer le point de départ pour une meilleure surveillance du phénomène et une mobilisation accrue des acteurs de santé publique et des politiques.
« C'est un premier pas dans la bonne direction, car le rapport apporte de nouveaux éléments et permet de lancer un message d'alerte fort, explique le Dr. Annette Heinzelmann, directrice médicale de MSF. Mais le constat qu'il dresse est encore incomplet : la situation dans de nombreux pays d'Afrique sub-saharienne n'y est pas documentée, faute de données disponibles et pour l’instant, seule la résistance aux antibiotiques de sept bactéries y est abordée ».
Sur certains de ses terrains d'intervention, MSF a pu observer et documenter la présence de résistances, parfois multiples, aux antibiotiques. Dans le projet de chirurgie reconstructive que l'organisation mène à Amman, 75% des infections constatées chez les patients en provenance d'Irak sont dues à des bactéries résistantes. Au mois de mars, cinq blessés soignés par les équipes MSF en Centrafrique présentaient des plaies infectées par des bactéries contre lesquelles les antibiotiques couramment utilisés étaient inefficaces. Les équipes ont ainsi dû acheminer dans le pays en urgence de l’imipénème, un antibiotique de dernière génération, dont le coût s’élève à environ 2 000 euros pour un traitement de six semaines.
Pour endiguer ce phénomène, il est urgent de mettre en place des mesures visant à limiter le développement et la transmission des bactéries résistantes, comme l'utilisation rigoureuse des antibiotiques, dont la prescription devrait être réservée à des praticiens formés et informés, la lutte contre la contrefaçon de médicaments, ainsi que l'application des règles d'hygiène et de stérilisation dans la pratique médicales, entre autres.
« Sans une action rapide et coordonnée, et en l’absence de nouvelles générations d’antibiotiques dans les années à venir, nous risquons à terme de nous retrouver démunis face à des infections de plus en plus résistantes, conclut le Dr. Heinzelmann. Concrètement, pour MSF cela signifierait ne plus pouvoir mettre en œuvre certaines activités médicales, comme la prise en charge des brûlures ou des infections osseuses ».

